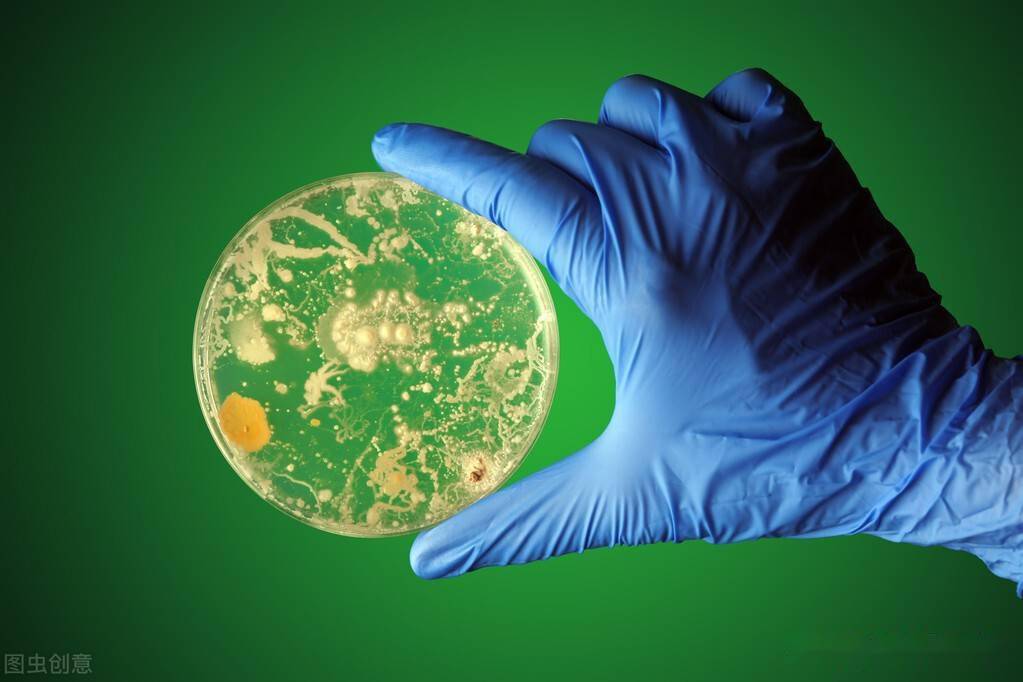
下一场农业革命的突破口在哪里?微生物,一个神秘的角色浮出水面

微生物资源

下一场农业革命的突破口在哪里?微生物,一个神秘的角色浮出水面
图片尺寸1023x682
小小微生物竟是重要战略资源
图片尺寸700x306
2无处不在的微生物
图片尺寸1280x720
《微生物的实验室培养》课件ppt
图片尺寸1080x810
资源微生物与人类的关系ppt
图片尺寸800x600
植物动物微生物-终.jpg
图片尺寸1299x648
美政府启动"国家微生物组计划",与"抗癌登月"并列国家级科研计划
图片尺寸777x630
微生物资源开发学大中专教材教辅 图书
图片尺寸682x1000
各种各样的微生物
图片尺寸1080x810
高清图片-微生物病毒(jpg).jpg
图片尺寸600x821
79个超强微生物知识
图片尺寸640x409
微生物多样性
图片尺寸960x598
特种微生物资源提供
图片尺寸428x272
小生命大作用,微生物与环境安全的那些事
图片尺寸640x337
2019年微生物资源.ppt 30页
图片尺寸1728x1296
海洋的突出贡献者微生物
图片尺寸960x620
中外共同发起微生物组测序合作计划5年内完成万种微生物模式菌株基因
图片尺寸1280x640
聚焦微生物资源研究技术高地第二届大湾区微生物资源调查研讨会召开
图片尺寸1284x717
微生物有助于生产
图片尺寸480x240
全世界铜荒严重微生物可以帮忙解决这个难题
图片尺寸640x640